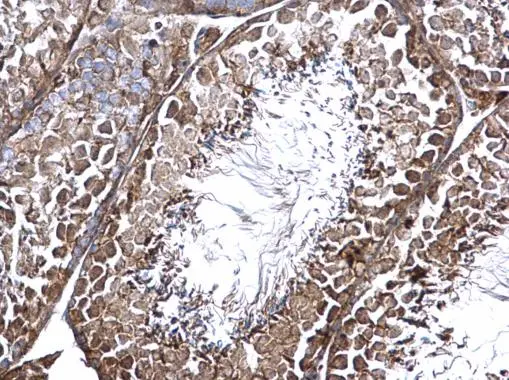

CNTROB antibody detects CNTROB protein at cytosol on mouse testis by immunohistochemical analysis. Sample: Paraffin-embedded mouse testis. CNTROB antibody (GTX120691) dilution: 1:500.
Antigen Retrieval: Trilogy? (EDTA based, pH 8.0) buffer, 15min
CNTROB antibody
GTX120691
ApplicationsImmunoHistoChemistry, ImmunoHistoChemistry Paraffin
Product group Antibodies
ReactivityHuman, Mouse
TargetCNTROB
Overview
- SupplierGeneTex
- Product NameCNTROB antibody
- Delivery Days Customer9
- Application Supplier NoteIHC-P: 1:100-1:1000. *Optimal dilutions/concentrations should be determined by the researcher.Not tested in other applications.
- ApplicationsImmunoHistoChemistry, ImmunoHistoChemistry Paraffin
- CertificationResearch Use Only
- ClonalityPolyclonal
- Concentration1 mg/ml
- ConjugateUnconjugated
- Gene ID116840
- Target nameCNTROB
- Target descriptioncentrobin, centriole duplication and spindle assembly protein
- Target synonymsLIP8, PP1221, centrobin, LYST-interacting protein 8, LYST-interacting protein LIP8, centrobin, centrosomal BRCA2 interacting protein, centrosomal BRCA2-interacting protein
- HostRabbit
- IsotypeIgG
- Protein IDQ8N137
- Protein NameCentrobin
- Scientific DescriptionCNTROB is a centrosomal protein that interacts with BRCA2 (MIM 600185) and is required for centriole duplication and cytokinesis (Zou et al., 2005 [PubMed 16275750]).[supplied by OMIM]
- ReactivityHuman, Mouse
- Storage Instruction-20°C or -80°C,2°C to 8°C
- UNSPSC12352203






